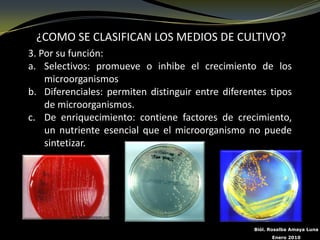
¿COMO SE CLASIFICAN LOS MEDIOS DE CULTIVO?
3. Por su función:
a. Selectivos: promueve o inhibe el crecimiento de los
    microorganismos
b. Diferenciales: permiten distinguir entre diferentes tipos
    de microorganismos.
c. De enriquecimiento: contiene factores de crecimiento,
    un nutriente esencial que el microorganismo no puede
    sintetizar.




                                                   Biól. Rosalba Amaya Luna
                                                         Enero 2010

Este documento describe los medios de cultivo y la esterilización en microbiología. Explica que los medios de cultivo proporcionan nutrientes y condiciones para el crecimiento microbiano, y se clasifican por consistencia, composición y función. También detalla cómo preparar los medios de cultivo mediante la disolución de medios deshidratados en agua y la esterilización posterior. Finalmente, resume los métodos de esterilización físicos como el calor húmedo y químicos como el hipoclorito de sod